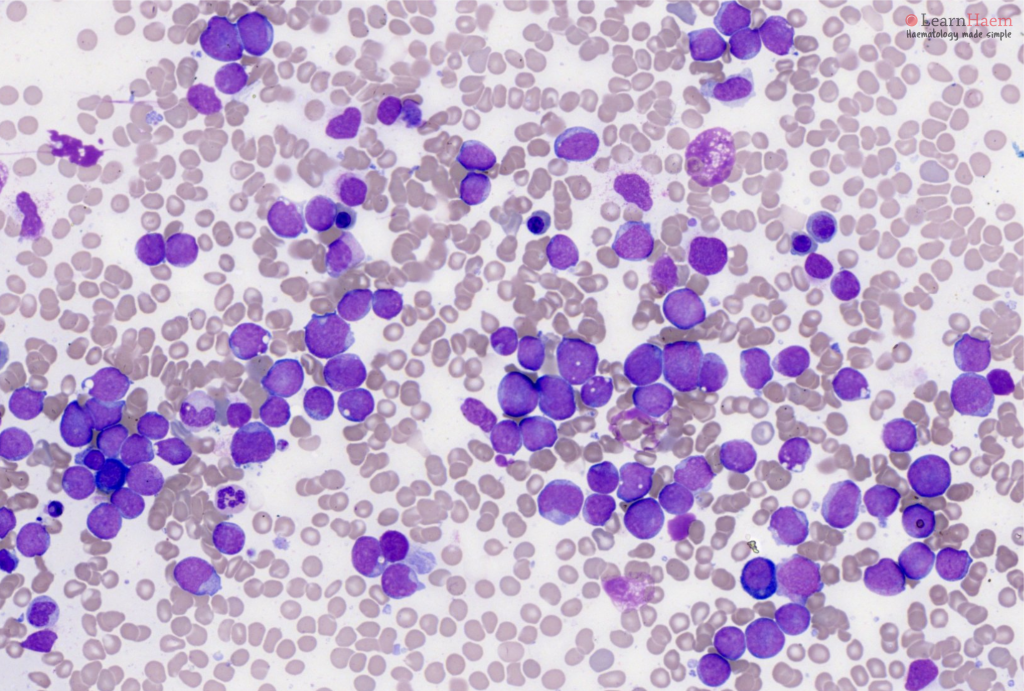

Putin Is Behaving More Like a Czar Than a Bolshevik am1 longevity Rio 2016: Russia Boasts No Olympic Team Is Cleaner am1 longevity Kenya: Anal Examinations of Homosexuals Legal, Court Rules am1 longevity Thousands Sign Up for Vote in U.K. Labour Leadership am1 longevity
am1 longevity Gold White Black Red Blue Beige Grey Price Rose Orange Purple Green Yellow Cyan Bordeaux pink Indigo Brown Silver

| Full Name: | |
| Title: | |
| Description: | |
| Rating Value: | |
| Time: | 2025-11-26 10:25:48 |